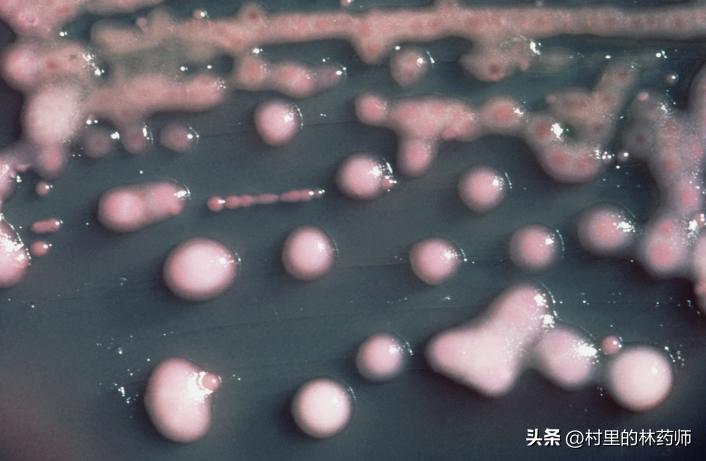
病人痰液有恶臭味是哪种细菌感染,痰液查出有细菌需要做支气管镜吗

最近查房时发现了一例感染催娩细菌的患者!
哦 my garden!

还有感染以后会促进生孩子的细菌吗?
强烈的求知欲让笔者花费了好几个晚上,最后。。。
先和大家说结果,这个菌全名叫催娩克雷伯菌, 同时也叫产酸克雷伯菌。肯定有学过微生物的,比较了解。可能会觉得笔者好像个智z啊,不过还是想将探寻的结果写出来。
笔者本来以为这个菌叫催娩克雷伯菌,就主要是感染孕妇的,而且染上以后还会促进生产(催生)!
查了文献才知道……
1、这个菌平时就悄无声息的存在着
催娩克雷伯菌(K. oxytoca)定植于健康和患病人群的皮肤、口腔、肠道和呼吸道。催娩克雷伯菌在健康人中的定植率较低。在健康人肠道定植率约为1.6%至9%,低于大肠杆菌的定植率(3.9%至87.7%)。
2、这个菌确实在患者中检出率更高
然而,在患者中,催娩克雷伯菌的定植率要高得多,例如在患有炎症性肠病(IBD)的患者中,催娩克雷伯菌的定植率为4.7%,在患有流感A的人群中为14%,在新生儿重症监护病房(NICU)和中级护理病房中为25.5%。此外,已发现产广谱β-内酰胺酶(ESBL)的催娩克雷伯菌在NICU患者中的肠道定植率为2.24%,孕妇中为3.3%,另一项研究报告称1.4%的成年重症监护病房(ICU)患者携带耐碳青霉烯的催娩克雷伯菌。(产ESBL的催娩克雷伯菌就是需要用更厉害的药物进行治疗的催娩克雷伯菌。ESBL是一种能够分解多种β内酰胺类药物的酶)
3、催娩克雷伯菌是孕妇尿道感染的常见病原体
催娩克雷伯菌不只能在人群中定植,同时能够引起感染。例如抗生素相关性出血性结肠炎、尿道感染 血流感染 腹腔感染 皮肤软组织感染等。

催娩克雷伯菌是尿路感染中相对常见的病原体,儿童和成人都可能感染,主要发生在孕妇、免疫功能受损的患者或患有泌尿系统疾病的人群。根据2009年至2018年间的抗微生物药物耐药性监测研究(SMART)计划,催娩克雷伯菌在墨西哥、中国、西班牙和美国的UTI分离株中的比例分别为1.3%(16/1,235)、0.7%(24/3,103)、1.9%(18/937)和3.6%(109/3,038)(137-140)。
在住院患者中,催娩克雷伯菌在所有细菌性尿路感染病原体中的比例在2.5%至3.5%之间。对于孕妇来说,催娩克雷伯菌在细菌性尿路感染病原体中似乎更常见,占比例为19.4%和38.1%,仅次于大肠杆菌。一些研究还报道了许多免疫功能受损、危重病或恶性肿瘤患者的催娩克雷伯菌引起的尿路感染。在大多数这类患者中,尿路感染的预后良好,但危重病患者常常在其他部位发生感染。此外,催娩克雷伯菌引起的尿路感染在患有泌尿系统疾病或病况的患者中也很常见,例如神经源性膀胱、肾结石、尿路手术、前列腺增生和*丸睾**梗死。在大多数这类情况下,尿路感染可以得到解决,但容易复发,因为潜在疾病通常仍然存在,可能导致长期的催娩克雷伯菌定植。
4、这个菌为什么叫催娩克雷伯菌?
国内微生物的名称都由国外的拉丁名称直接翻译而来。这个菌的拉丁名称是klebsiella oxytoca。德国医生埃德温·克雷伯(Edwin Klebs)1887年首次描述了肺炎克雷伯菌Klebsiella pneumoniae,对细菌学和传染病学做出了重要贡献。Klebsiella 菌属以德国医生埃德温·克雷伯的姓氏命名,以纪念他对医学研究的贡献。
催娩克雷伯菌与肺炎克雷伯菌同属克雷伯菌属,肺炎克雷伯菌是单一的主要物种,类似于铜绿假单胞菌和不动杆菌,正在三级医院发展多重耐药性。在克雷伯菌中,催娩克雷伯菌的分离频率越来越高。该菌在合并多种疾病和免疫功能受损的住院患者中较为常见。克雷伯菌属,包括催娩克雷伯菌,正在成为越来越重要的病原体,并与住院时间延长和发病率增加有关。
催娩克雷伯菌的翻译是根据其拉丁学名Klebsiella oxytoca而来。"Klebsiella"克雷伯的姓氏命名。而"oxytoca"是源自希腊语"oxy"(意为酸)和"toca"(意为产生),表示该细菌能够产生酸。根据官方CICC翻译,该菌翻译为产酸克雷伯氏菌。

但是在人卫版《医学微生物学》的教材上,翻译为催娩克雷伯菌。这是啥原因呢?Oxytoca不仅可以翻译为产酸,由于这个单词和oxytocin(催产素)接近,不少人也将之翻译为“催娩”。
5、这个菌用什么药治疗?
由于催娩克雷伯菌是肠杆菌目(Enterobacterales)的成员,因此对于由催娩克雷伯菌复合体引起的感染,抗菌治疗与其他肠杆菌目物种(如肺炎克雷伯菌菌 、大肠杆菌)的感染基本相同。值得注意的是,在监测计划(如SENTRY)和已发表的报告中,催娩克雷伯菌复合体对头孢他啶、碳青霉烯、阿米卡星和左氧氟沙星等常用抗菌药物的耐药率相对较低。因此,根据患者的疾病严重程度、免疫状态和感染部位等因素,许多常用的抗菌药物,包括β-内酰胺类药物(如头孢菌素、碳青霉烯和哌拉西林-他唑巴坦)和非β-内酰胺类药物(如阿米卡星、多粘菌素、喹诺酮类药物、替米考星和磺胺甲噁唑)都可以作为治疗催娩克雷伯菌复合体感染的选择。

复合体菌株与其他肠杆菌目物种共享碳青霉烯耐药机制,特别是与肺炎克雷伯菌共享碳青霉烯耐药机制。对于复合体耐碳青霉烯菌株的抗菌治疗与对碳青霉烯耐药肠杆菌(CRE)的抗菌治疗相同。针对CRE的抗菌治疗通常根据感染部位(尿路感染或尿路以外的感染)、耐药谱(对美罗培南的敏感性以及对厄他培南的耐药性)和碳青霉烯酶类型(如丝氨酸β-内酰胺酶[KPC]或氧化酶-48 [OXA-48])进行分层。对于尿路以外的感染,通常推荐使用含有新型非β-内酰胺酶*制剂抑**的联合治疗。
催娩克雷伯菌并不能够催生,该名字的由来是Oxytoca一词多义造成的。官方一般译为“产酸克雷伯菌”
你也有对奇怪名字的探究趣事吗?快来说说吧!
参考文献
1、Klebsiella oxytoca: An emerging pathogen?2016
2、Klebsiella oxytoca Complex: Update on Taxonomy, Antimicrobial Resistance, and Virulence 2022